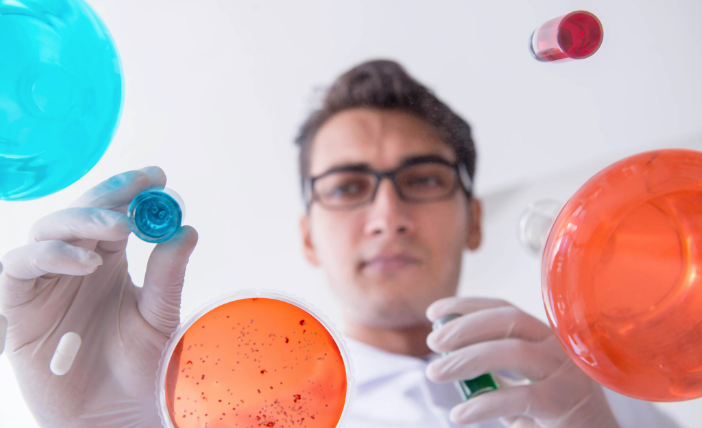
Cancer Research

Magnox
Effectively managing change in technology and people management
The problem
Attract and retain talent whilst undergoing technology and business change.
A change in mandate meant that the outlook for Magnox changed from an organisation in the process of winding down to a business that was growing in terms of scope and, consequently, staff. This change created several immediate challenges and accelerated the need to address some existing issues.
Attracting new talent and retaining existing personnel with specific skills in a competitive market was a key consideration for Magnox. Part of this could be addressed by improving recruitment and on-boarding processes. Other elements could be tackled by implementing a more sustainable approach to performance management by moving away from the existing paper-based performance management processes and increasing the focus on development and wellbeing. There was also a need to shift the mindset of the organisation away from time limited operations to a much longer-term outlook.
Magnox’s transformed mandate also meant some system changes would be needed, particularly around their existing Unit4 implementation, which had been in place for several years.
During that time, heavy customisations had already led to additional expenses for support and significant challenges in relation to system updates. The team accepted that migrating to the Unit4 cloud would be the best approach, but this created its own challenges around redefining their processes and reducing their reliance on customisations. They also wanted to future-proof the new Unit4 implementation – to make sure the new deployment, in the cloud, would weather and accommodate Magnox’s future.
Additionally, in order to support their increased recruitment requirements, the Magnox team were planning to implement a new piece of software – Hireserve Applicant Tracking System (Hireserve ATS). Ideally, they wanted this to be fully integrated with the Unit4 ERP to facilitate an efficient and effective end-to-end recruitment process.
The solution
Embridge worked alongside Magnox and Unit4 to support the changes in terms of technology and people management.
Hireserve integration
Specifically, Embridge provided an integration solution to support the implementation of the Hireserve ATS coupled with specialist change management knowledge and additional resource to the project.
The Hireserve ATS integration solution encompassed:
- User accounts – enables synchronisation of user records between Unit4 ERP and Hireserve ATS
- Vacancies – means the team can manage the ‘authority to recruit’ process within Unit4 ERP, using online forms and leveraging workflow and existing hierarchies or Delegation of Authorities to obtain approval, as well as pass mapped approved vacancy details across to Hireserve ATS, creating the vacancy in draft
- Applicants – automatically creates new resource records in the Unit4 ERP once pre-employment checks have been completed and a conditional offer accepted
Each part of the solution was set-up and configured in-line with Magnox’s requirements and the integrations are all provided on a monthly subscription basis.
Change Management
Working alongside the Magnox team, Embridge’s role was to help the organisation shape its thinking in regard to a new approach for performance management, understand the impact, and then design and co-deliver a change management plan to enable that change.
Using the Prosci Change Management best practice approach, Embridge helped analyse and understand the potential change, and identify success and adoption measures to monitor return on investment and the development of a change management plan. Early on, this work involved helping the Magnox project team to formulate, communicate, and share their ideas.
This enabled them to consult with the wider HR team, Unions, the Programme Board, and managers to source their input and build their understanding of what the project was looking to achieve. Embridge also supported the development of their branding for the new approach, including communications and training materials such as videos and quick cards.
A key part of the project was facilitating a pilot of the new online system for performance management, facilitated by Embridge, which demonstrated exactly what the workflow of continuous performance management would look like.
This pilot also provided a lot of feedback and data on what both employees and managers might need to help them engage with the system and the new approach. This exercise helped show readiness for go-live, build confidence in the system, and inform communications and training support, ensuring managers’ and employees’ needs were met, enabling a successful launch.
The Embridge team was able to build a strong working relationship with the Magnox project team through regular meetings and really understanding the challenges. One of our change management experts guided the Magnox team through the entire process and provided support as needed along the way.
Additionally, Embridge proposed a sustainment plan to continue embedding the new performance management approach throughout the year and within the appraisal cycle. This sustainment plan would ensure that the best practice approach was maintained consistently both during the project and post go-live for continued realisation of benefit and enduring positive outcomes.
It’s great rolling out a new application or a new system to the business, but if you don’t take people on the journey, it won’t be adopted properly. And you don’t get your return on investment as quickly as you would do if you did proper change management.
Mark Kent Head of IT Programme Delivery
The result
Overall, Embridge’s work streams were delivered on time and budget, and with a positive response from the organisation.
In terms of the Hireserve deployment and subsequent integration, shortly after the deployment went live, Magnox was able to advertise 250 live job vacancies – a huge increase compared to the handful of roles that they previously advertised for their legacy systems.
Large scale efficiencies have been realised as a result of the new solution, including the time taken to advertise roles was cut from two weeks to two days thanks to reductions in manual work, including administration related to GDPR. The team are also now able to deal with a much larger volume of applicants.
Positive cultural change has emerged as Magnox has found it easier to upskill staff on the use of new technologies and processes, and they have brought in new, capable people to introduce new ways of doing things.
They have also seen improvements in engagement, with a recent staff survey attracting a 75% response rate – historically high for Magnox – as well as approximately 22,000 comments for consideration.
Transformation in practice
- Autotrader
 Case Study
Case StudyAutotrader
- Cancer Research
Case Study
Case StudyCancer Research
- Cherwell District Council
 Case Study
Case StudyCherwell District Council
- Core Assets Group
 Case Study
Case StudyCore Assets Group
- Embridge Managed Services
 Case Study
Case StudyEmbridge Managed Services
- Guildford Borough Council
 Case Study
Case StudyGuildford Borough Council
- Magnox
 Case Study
Case StudyMagnox
- Quartzelec
 Case Study
Case StudyQuartzelec
- RSBG UK
 Case Study
Case StudyRSBG UK
- Shakespeare Birthplace Trust
 Case Study
Case StudyShakespeare Birthplace Trust
- Skills Development Scotland
 Case Study
Case StudySkills Development Scotland
Start the conversation
Keep change moving, empower your teams, and embed improvements that scale with your organisation.
